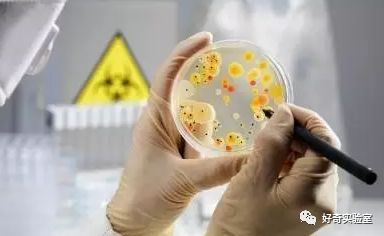
吹生日蛋糕蜡烛把假牙吹出来了,吹生日蛋糕蜡烛

小时候
一年中除了过年这几天
最期待的就是过生日了
通常妈妈会做一桌好菜
还会收到很多礼物
最关键的就是能吃到蛋糕

不过吃蛋糕之前
会有个隆重仪式
点蜡烛
一起唱生日歌
那是必须的
最后寿星一口气把蜡烛吹灭
然后才能切蛋糕

据说生日吹蜡烛的习惯
起源于古希腊时期
那时候的女神阿尔特密斯
将点燃的蜡烛用来装饰蛋糕
吹灭蜡烛时会有一股烟
这股烟雾会在空中慢慢上升
就像是信徒们的祈祷传递到神那里
后来就演变成了许愿吹蜡烛的习惯

按说这吹蜡烛的动作
寓意很美好
从来没人觉得这是个问题
但是美国克莱普逊大学有个教授
名叫保罗•道森
他给女儿过生日的时候
女儿吹蜡烛的动作
让他想到了一个问题
这一口气吹下去
会不会把嘴里的细菌
全吹在蛋糕上?

很多人都会觉得
没这么夸张吧!
不就是一口气嘛
不过仔细想想还真是有可能的
虽然看起来只是一口气
但是里面绝对是有口水
只不过很细小看不见
特别是一堆小朋友一起吹蜡烛
那场面你想象一下

意识到这个问题
道森教授立刻着手开始实验
实验没有用真正的蛋糕
而是将泡沫块表面盖上了锡箔
上面涂上了糖霜
然后他们在假蛋糕
插了17根蜡烛
让志愿者全部吹灭蜡烛
为了为求真实
志愿者在吹蜡烛前都吃了披萨饼
充分刺激唾液分泌

蜡烛吹灭后
取下锡箔纸上的唾液样本
放进培养皿
进行细菌培养
检测结果有点惊人
尽管不同人吹气
造成的“污染”效果不同
不过平均下来
蛋糕上的细菌数量
在吹过蜡烛后增加了 14倍
后来日本人
又再次做了这个实验
并且将这个实验扩展到
生活中常出现的各种场合
比如吃热炸猪排时吹凉
同样得出了细菌数会增加的结论

这让小编想到了很多场景
热水太烫了吹一下
饭太烫了吹一下
自己吃倒无所谓
但很多时候都是大人帮小孩吹
或者给你的妹子献爱心
小孩子和妹子们
本身抵抗力就差
……

是不是很恐怖
那以后都别吹蜡烛了?
其实不用太过担心
一、
空气中本身就有细菌
任何东西暴露在空气中
就算不朝它吹气
也会有细菌附着在上面

二、
人类口腔中的细菌大多无害
即使是因吹蜡烛导致细菌传播
造成感染的概率也相当低
即使这样做上10万次
你生病的可能性依然很小
因为人类口腔中细菌大多无害
就是有点恶心
毕竟在吃人家的口水
你说是吧!

当然
有一种情况应该注意
不要吹蜡烛了
如果你得了感冒
或者其他传染性疾病时
就算是过生日也最好不要吹蜡烛
真的就有可能传染给别人
来源:好奇实验室
编辑:AI